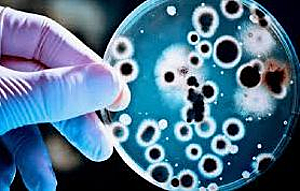
La Penicilina

-
Se inició en Italia en el siglo XIV y se extendió por toda Europa favorecido por el invento de la imprenta. Imagen =
https://revistaacropolis.org/2019/06/11/el-humanismo-en-el-renacimiento/ -
-
Tommaso di ser Giovanni di Mone Cassai llamado Masaccio
La composición a base de pocas figuras esenciales y la plasmación natural de la luz definen su estilo característico.
Obra maestra la expulsión del Paraíso (1426-1428), que pintó para la capilla Brancacci de Santa Maria del Carmine, en Florencia. https://www.biografiasyvidas.com/biografia/m/masaccio.htm -
FILIPO BRUNELESCHIL (1377 - 1446)
Fue un arquitecto, escultor y orfebre renacentista italiano.
Es conocido, por su trabajo en la cúpula de la catedral de Florencia Il Duomo. Sus profundos conocimientos matemáticos y su entusiasmo por esta ciencia le facilitaron el camino en la arquitectura. https://www.monografias.com/trabajos90/renacimiento-y-sus-representantes/renacimiento-y-sus-representantes.shtml
Imagen https://historia.nationalgeographic.com.es/a/cupula-brunelleschi_7970/3 -
La imprenta: Es sin duda uno de los mas importantes pues permitió la rápida expansión de las nuevas ideas renacentistas. Copia de la primera imprenta Johan Gutenberg https://www.laimprentacg.com/quien-invento-la-imprenta/
-
Piero della Francesca Dominó la técnica de la perspectiva y el claro oscuro. La flagelación http://www.plasticayarte.com/2014/04/la-flagelacion-de-piero-della-francesca.html
-
LEON BATISTA ALBERTI (1404-1472)
Fue un arquitecto, matemático y poeta italiano. Además de estas actividades principales, también fue criptógrafo, lingüista, filósofo, músico y arqueólogo. Es una de las figuras artísticas más polifacéticas del Renacimiento. La fachada de Santa Maria Novella (1458-1470) http://salcedocarlosha2.blogspot.com/ -
Sandro Botticelli
Se inclinó por un estilo basado en la delicadeza, la gracia y un cierto sentimentalismo.
La primavera, 1480-81, Galería de los Uffizi, Florencia. https://www.descubrirelarte.es/2015/09/21/sandro-botticelli-un-pintor-neoplatonista.html -
PERUGINO (1450-1523)
Vivió y trabajó esencialmente en Perugia, Se cree que se formó en Florencia con A. Verrocchio y está documentada su presencia en Roma, donde pintó en la Capilla Sixtina el famoso fresco de la Entrega de las llaves a san Pedro. https://www.monografias.com/trabajos90/renacimiento-y-sus-representantes/renacimiento-y-sus-representantes.shtml Imagen https://es.m.wikipedia.org/wiki/Archivo:Entrega_de_las_llaves_a_San_Pedro_(Perugino).jpg -
MIGUEL ÁNGEL (1475-1564)
Escultor, pintor y arquitecto italiano. La Piedad https://www.biografiasyvidas.com/biografia/m/miguel_angel.htm -
DONATO BRAMANTE
Arquitecto y pintor italiano.
Aunque no llegara a realizarse, la expresión suprema del talento de Donato Bramante fue el proyecto de la nueva Basílica de San Pedro, al que dio comienzo desde 1503, por impulso ambicioso del papa Julio II https://www.ecured.cu/Bas%C3%ADlica_de_San_Pedro -
LEONARDO DA VINCI (1452-1519)
En el plano artístico, Leonardo conforma, junto con Miguel Ángel y Rafael, la tríada de los grandes maestros del Cinquecento, y, pese a la parquedad de su obra, la historia de la pintura lo cuenta entre sus mayores genios. Por los demás, es posible que de la poderosa fascinación que suscitan sus obras maestras (con La Gioconda a la cabeza 1503-1507). https://www.biografiasyvidas.com/monografia/leonardo/ -
Giorgio Barbarelli (1478-1510) Maestro del dibujo y la composición, Giorgione nunca se sometió a los límites de la línea mostrándose igual de ducho con el cromatismo y trabajo. La venus Dormida https://arte.laguia2000.com/pintura/venus-dormida-giorgione
-
RAFAEL SANDIO (1483-1520)
Pintor y arquitecto italiano.
Junto con la escuela de Leonardo da Vinci y Miguel Ángel Buonarrotti, es una de las más excelsas realizaciones de los ideales estéticos del Renacimiento. La escuela de Atenas
https://www.biografiasyvidas.com/biografia/r/rafael.htm -
TIZIANO (1490-1576)
Como muchos de sus últimos trabajos, la última obra de Tiziano, la Piedad (1576) es una dramática escena de sufrimiento en un ambiente nocturno. Fue la pintura escogida para decorar su tumba (Galería de la Academia de Venecia). https://es.wikipedia.org/wiki/Tiziano -
ANTONIO DA SANGALLO EL JOVEN (1483-1546) Arquitecto italiano.
Su obra más importante es el Palacio Farnesio, concebido según el tipo florentino de tres pisos, que sería continuado por Miguel Ángel, vignola, y Giacomo della porta. Construcción (1515 - 1589) https://www.biografiasyvidas.com/biografia/s/sangallo_el_joven.htm -
El origen del primer microscopio óptico es objeto de debate, pero la mayoría de los estudiosos coinciden en que la invención del microscopio compuesto puede atribuirse a Zacharias Janssen. https://comprarmimicroscopio.com/microscopio-zacharias-janssen/
-
Galileo Galilei, construyo un telescopio a partir de un invento del Holandés Hans Lippershey, siendo el primero en usarlo para el estudio de los astros, descubriendo los cráteres de la luna, las lunas de júpiter, las manchas solares y las fases de Venus. https://www.biografiasyvidas.com/monografia/galileo/fotos6.htm
-
En el siglo XIX el humanismo se convierte en un campo de batalla, donde se tiene repercusiones en la vida cotidiana del individuo y de los pueblos.
La historia pasó a ser una disciplina ya que puso en marcha investigaciones históricas. Al mismo tiempo se inició la publicación de recopilaciones de fuentes históricas y aparecieron las primeras grandes obras históricas. http://recursostic.educacion.es/secundaria/edad/4esohistoria/quincena1/imagenes1/quincena1_texto.pdf -
Richard Trevithick, ingeniero e inventor de origen inglés, fue el encargado de diseñar y desarrollar la primera locomotora a vapor de la historia; la cual podía arrastrar un convoy con un peso de cinco toneladas y recorrer unos 15 km a una velocidad de 20 km/h. Su principal uso en esa época tuvo lugar en las minas, con el objetivo de cargar los minerales. https://www.historiando.org/ferrocarril/
-
"La figura de Napoleón Bonaparte emergió durante la Revolución Francesa, y con el paso de los años se agigantó hasta convertirse en uno de los símbolos militares y políticos más importantes de la historia de Europa. Como emperador, dominó su país y lo embarcó en una espiral expansionista. https://historia.nationalgeographic.com.es/a/proclamacion-napoleon-como-emperador_8185
-
“Este famoso naturalista inglés fue quien postuló que todas las especies de seres vivos han evolucionado con el tiempo a partir de un antepasado común mediante un proceso denominado “selección natural”. Su teoría de la evolución forma la base de la síntesis evolutiva moderna y constituye una explicación lógica que unifica las observaciones sobre la diversidad de la vida" https://www.ecured.cu/Charles_Darwin
-
La primera bicicleta recibió el nombre de máquina delante, la cual fue construida por el alemán KARL VON DRAIS, la cual consistía en unas varas, las cuales tenían incorporadas las ruedas y el manubrio, lo que era suficiente para que una persona se lograra trasladar de un lugar a otro con tan solo hacer giros con sus piernas sobre los pedales.
-
"Pensador socialista y activista revolucionario de origen alemán. Raramente la obra de un filósofo ha tenido tan vastas y tangibles consecuencias históricas como las de Karl Marx: desde la Revolución Rusa del 1917 y hasta la caída del muro de Berlín en 1989, casi la mitad de la humanidad vivió en países mantenidos por gobiernos políticos que se declararon herederos de su pensamiento" https://psicologiaymente.com/miscelanea/personajes-historicos-mas-importantes
-
"Fue un químico francés cuyos descubrimientos tuvieron un enorme impacto en los diversos campos de las ciencias naturales. A él se le debe honor a la técnica de “pasteurización”. Además, rechazó categóricamente la teoría de la generación espontánea y desarrolló la teoría germinal de las enfermedades infecciosas" (psicologia y mente, s.f.)
-
"La fecha con la que se oficializó la invención de la fotografía fue 1839, sin embargo, ya desde años antes se habían conseguido realizar las primeras fotografías. La primera de ellas, de 1826, es atribuida a Joseph Niépce, que a la postre sería reconocido como el inventor de la fotografía" https://www.ngenespanol.com/traveler/la-primera-imagen-de-la-historia-fotografia/
-
Es un movimiento artístico, literario y filosófico, es reconocido como un estilo literario. En el se suele asociar o emparentar con el realismo, movimiento del cual el naturalismo tomaría algunos de sus aspectos. Algunas de las características del naturalismo son el determinismo, pesimismo, el lenguaje impersonal, el rechazo del Romanticismo, el acercamiento entre filosofía y ciencia. https://www.lifeder.com/caracteristicas-del-naturalismo/
-
Thomas Edison, ilustre por ser el creador de más de un millar de inventos tales como la bombilla, la lámpara incandescente, el fenógrafo o el proyector de películas, sólo pudo asistir a la escuela durante un período de tres meses. https://psicologiaymente.com/miscelanea/personajes-historicos-mas-importantes
-
Fue creado por Antonio Meucci, el cual recibió el nombre de teletrófono, posteriormente fue llamado teléfono. Este invento y su desarrollo posterior dió un fuerte impulso a las comunicaciones mediante el uso de tecnología producida con el uso de la electricidad como conductora.
-
Inventor, ingeniero mecánico, ingeniero electricista y físico de origen serbio afincado en Estados Unidos. Se le considera como el promotor más ilustre del nacimiento de la electricidad comercial. También es famoso por sus numerosos y revolucionarios logros en el campo del electromagnetismo, desarrollados a principios del siglo XIX y principios del XX. https://psicologiaymente.com/miscelanea/personajes-historicos-mas-importantes
-
Se produjo una vez que el sistema económico conocido como capitalismo llegó a una mayor cantidad de países. Las innovaciones técnicas y científicas, además del descubrimiento de nuevas fuentes de energía, impulsaron su desarrollo. la segunda revolución fue más expansiva y alcanzó al resto de Europa occidental, los Estados Unidos y Japón. http://contenidos.ceibal.edu.uy/fichas_educativas/_pdf/historia/mundo/008-la-segunda-revolucion-industrial.pdf
-
“La mente es como un paracaídas, únicamente sirve si lo tenemos abierto”. Físico alemán es considerado el científico más importante y popular del siglo XX. En 1905, siendo todavía un joven investigador desconocido, publicó su teoría de la relatividad espacial. Diez años más tarde, presentaría la teoría de la relatividad general, lo que reformuló por completo el concepto de gravedad.” https://psicologiaymente.com/miscelanea/personajes-historicos-mas-importantes
-
“Aunque el conflicto comenzó en octubre de 1899, no sólo marcó el final del siglo XIX, sino la entrada del XX en la historia, al extenderse hasta noviembre de 1902. Un completo relato de los hechos principales que tuvieron lugar en la sangrienta contienda que duró mil días y dejó más de cien colombianos tendidos en los campos de batalla" https://www.ecured.cu/Guerra_de_los_mil_d%C3%ADas_(Colombia,_1899-1902)
-
La ambición humana por descubrir nuevos territorios, conquistarlos y agregarlos a su imperio, obligó la búsqueda de medios de transporte cada vez más rápidos y eficientes. Desde el simple caminar al tren pasaron miles de años. http://www.bbc.co.uk/spanish/seriesigloxx06a.shtml
-
Ocurrieron hechos determinantes en la historia de la humanidad, los avances de la tecnología, la medicina; generando cambios en el ámbito social y político, se puso fin a la esclavitud; liberación de la mujer en la mayor parte de los países; pero también por crisis y despotismos humanos, que causaron efectos como las Guerras Mundiales; el genocidio y el etnocidio, las políticas de exclusión social y la generalización del desempleo y de la pobreza. https://www.ecured.cu/Siglo_XX
-
Guglielmo Marconi fue el inventor de la radio, logrando la primera transmisión en 1901, generando cambios y siendo accesibles a las personas. Hoy en día, los transmisores de radio están en todas partes, desde el hogar, el automóvil, la oficina de trabajo etc. https://es.wikipedia.org/wiki/Guillermo_Marconi
-
Un científico alemán dio con la teoría la relatividad, cuya definición recae en la confirmación de que la realización de eventos físicos en el tiempo y espacio son relativos al estado de movimiento del observador y pueden variar en función de la velocidad, en este caso, de la luz. https://www.vix.com/es/imj/mundo/165632/10-grandes-sucesos-que-marcaron-el-siglo-xx-y-deberias-conocer
-
Fue una monja católica que por más de 45 años ayudó a los más vulnerables, mientras predicaba su ideología de la revolución del amor. En palabras del Papa Francisco, la Madre Teresa fue una “incansable trabajadora de la misericordia”. En 1950 fundó la congregación de las Misioneras de la Caridad en Calcuta – India- y desde allí extendió su legado y mensaje de paz por todo el mundo https://idiomasblendex.com/grandes-personajes-del-siglo-xx/
-
Matemático, lógico, científico de la computación, criptógrafo, filósofo. Considerado uno de los padres de la ciencia de la computación y precursor de la informática moderna. Proporcionó una influyente formalización de los conceptos de algoritmo y computación: la máquina de Turing. Formuló su propia versión que hoy es ampliamente aceptada como la tesis de Church-Turing.
https://www.ruizhealytimes.com/un-dia-como-hoy/de-1912-nace-el-matematico-logico-cientifico-de-la-computacion-criptografo-y -
La Primera Guerra Mundial es el primero de los grandes conflictos bélicos a nivel mundial. Los grupos combatientes fueron la Triple Entente (Reino Unido, Francia y el Imperio Ruso) y la Triple Alianza (Alemania y Austro Hungría). La guerra finalizó con la petición de armisticio por parte de Alemania, y poco después se firmó el Tratado de Versalles. https://academiaplay.es/siglo-xx-20-acontecimientos-2/
-
En 1925 el inventor escocés John Logie Baird realiza la primera experiencia real utilizando discos, uno como emisor y otro como el receptor, que estaban unidos al mismo eje para tener un giro sincrónico (separados por 2 mm) La televisión se trata de un sistema para la transmisión y recepción de imágenes y sonido que simulan movimiento, a distancia que emplea un mecanismo de difusión.
https://www.sutori.com/item/1925-television-un-inventor-escoces-en-1925-john-logie-baird-efectua-la-prime-2aa1 -
El británico Alexander Fleming revolucionó la medicina moderna con el descubrimiento de la Penicilina, con la que se consiguió tratar enfermedades que hasta la fecha se consideraban incurables. La penicilina fue extraída de los cultivos hongo Penicillium notatum, que se emplea para combatir las enfermedades causadas por ciertos microorganismos.
https://www.sololistas.net/hechos-historicos-mas-importantes-del-siglo-xx.html -
“El capitalismo ingresó al siglo XX como el sistema dominante. Los imperios coloniales, la expansión del comercio, la pujanza de Estados Unidos lo demostraba así. Al pasar la primera década, estallaba la Primera Guerra Mundial, que frenaba la expansión del comercio; ganaba fuerza el proteccionismo económico y el comunismo conquistaba Rusia.”
http://www.bbc.co.uk/spanish/seriesigloxx01c.shtml -
"La Primera Guerra Mundial dejó una Alemania derrotada política y económicamente. El antiguo Imperio alemán, prácticamente desmantelado, tras la crisis económica de 1929 sólo había frustración. esto constituía un excelente caldo de cultivo para la emergencia de los totalitarismos que empezaban a imponerse en la Europa de entreguerras, como el Adolf Hitler."
https://www.semana.com/educacion/articulo/historia-de-hitler-el-nazismo-y-la-segunda-guerra-mundial/471471 -
El enfrentamiento bélico más destructivo del siglo, que enfrentó a las Potencias del Eje: la Alemania nazi, la Italia fascista y el Imperio del Japón, contra las fuerzas aliadas de Inglaterra, Francia, Estados Unidos, China, la Unión Soviética y otros países allegados a ambos bandos, en una guerra de destrucción total. En el marco de ella se produjo el Holocausto judío y se arrojaron las dos bombas atómicas sobre Hiroshima y Nagasaki. https://www.caracteristicas.co/siglo-xx/#ixzz6Fl28OVfj
-
La persecución a más de 6 millones de judíos por parte del ejército nazi liderado por Adolf Hitler y su posterior encierro en campos de concentración se convirtió en el colofón de un ascenso al poder del Führer durante los años 30 que desencadenó una Segunda Guerra Mundial aún más cruenta y alteró la estabilidad del continente europeo que pagaría las consecuencia durante las décadas sucesivas.
https://www.vix.com/es/imj/mundo/165632/10-grandes-sucesos-que-marcaron-el-siglo-xx-y-deberias-conocer -
Como respuesta al ataque por parte de los japoneses a la base naval estadounidense de Pearl Harbor, los estadounidenses planificaron su venganza arrojando el 6 y 9 de agosto de 1945 sendas bombas atómicas sobre las ciudades de Hiroshima y Nagasaki. De este modo, provocaron 246 mil muertes. https://www.vix.com/es/imj/mundo/165632/10-grandes-sucesos-que-marcaron-el-siglo-xx-y-deberias-conocer
-
"Informático y empresario estadounidense, fundador de la compañía informática Microsoft. La fortuna de este precoz programador que a los 31 años ya era multimillonario, procede del éxito de su arrollador sistema operativo, el MS-DOS (1981) que evolucionaría hasta convertirse en el omnipresente sistema Windows. http://www.piensaeningles.com.co/index.php/component/k2/item/967-filosofia-de-bill-gates-de-microsoft-corporation
-
El 21 de julio de 1969 el comandante estadounidense Neil Armstrong de la misión espacial tripulada Apolo 11 de Estados Unidos, fue el primer ser humano en pisar la luna. Mientras descendía por la escalera del módulo, Armstrong proclamó la célebre frase de la historia: "Este es un pequeño paso para el hombre, pero un gran salto para la humanidad" https://www.sololistas.net/hechos-historicos-mas-importantes-del-siglo-xx.html
-
Es el cambio de la tecnología mecánica, eléctrica y analógica a la tecnología digital, que ha tenido lugar desde el 1980 y continúa hasta la actualidad. Implícitamente, el término también se refiere a los cambios radicales producidos por la informática y la tecnología de la comunicación durante la segunda mitad del siglo XX. https://www.ecured.cu/Revoluci%C3%B3n_digital
-
Sociedad del big data, la cuarta revolución y el desarrollo del pensamiento critico y creativo
-
Se comienza a desarrollar y fortalecer la cultura digital. Los cambios de la sociedad exigen un mayor liderazgo social de la universidad. Los cambios que se dan exige repensar los proceso de formación en las universidades. Comienza los procesos de automatización de las cosas.
-
-Uso masivo de las tecnologías.
-se masifica la tecnología inhalambrica.
-mayor conectividad.
-uso del big data.
-Se promueve la IA. Nace el Dataismo como religión; es un término que ha sido utilizado para describir la mentalidad, filosofía o religión creada por el significado emergente del Big Data, la Inteligencia Artificial y la Internet de las cosas (IoT). https://www.youtube.com/watch?v=U8jGCy2QG9Y https://www.youtube.com/watch?v=w4vsFKMO7XA -
-
El primero en pasar el Test de Turing fue Eugene Goostman, un chatbot desarrollado por programadores que simularon la personalidad de un adolescente Ukraniano. Este aspecto jugó a su favor durante el test: Cómo el no estaba imitando la conversación de un adulto, fue capaz de mimetizar naturalmente su falta de conocimiento, característica de la edad.
-
La sociedad requiere de humanos que se adapten a los continuos cambios, que tengan pensamiento flexible. Uso permanente de la información.
-
Google libera TensorFlow: su sistema de aprendizaje de código abierto. https://www.europapress.es/portaltic/software/noticia-google-libera-tensorflow-sistema-aprendizaje-codigo-abierto-20151110131924.html)
-
Incorporación de la IA a los trabajos de las personas. https://lab.elmundo.es/inteligencia-artificial/trabajo-robots.html
-
Nacen los primeros humanos modificados genéticamente. Se requiere mantener la discusión sobre la ética en el uso de la tecnología https://cnnespanol.cnn.com/2019/12/30/cientifico-chino-que-modifico-los-genes-de-bebes-mellizas-es-sentenciado-a-3-anos-de-carcel/ https://www.youtube.com/watch?v=TF-AbEICphY https://www.youtube.com/watch?v=XJDBN2j9rr4
-
Hay grandes preocupaciones por -La perdida de la privacidad.
-Aumento de la vigilancia por los diferentes gobiernos.
Reemplazo de las personas por el uso de maquinas
Falta de legislación en torno al uso de los biodatos de las personas.
-Falta de ética en los procesos modificación genética.
La deshumanizaron de la sociedad Perdida de la privacidad.
https://www.youtube.com/watch?v=NPE7i8wuupk Deshumanización de la sociedad.
https://www.youtube.com/watch?v=PC77nQq2czU
A list shows items. A timeline shows sequence.
Use Timetoast to make dates, milestones, and turning points easier to understand in a clear visual format. Timetoast is a timeline maker for work, school, research, and stories.